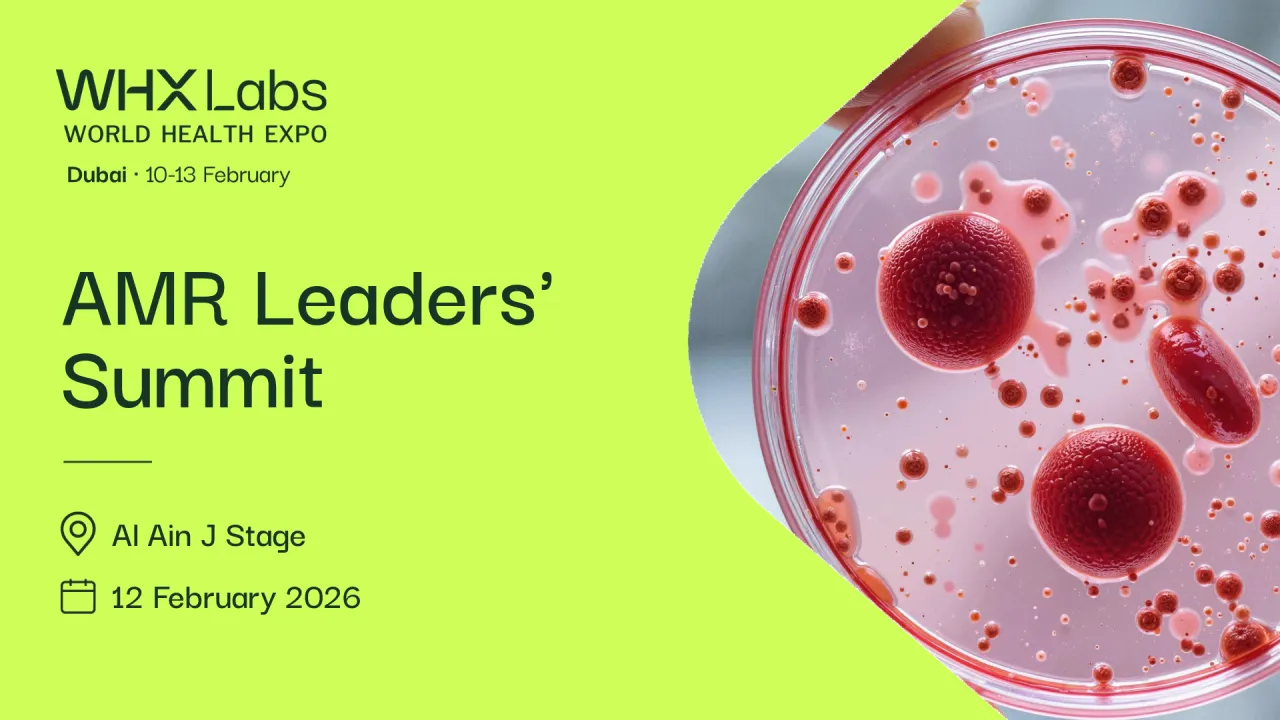
The power of connection: Scaling AMR initiatives through Abu Dhabi’s one health ecosystem

The power of connection: Scaling AMR initiatives through Abu Dhabi’s one health ecosystem
Friday, February 13, 2026 11:30 AM to 12:00 PM · 30 min. (Asia/Dubai)
Information
Please note: Standard and Dual Ticket holders must upgrade to a Delegate Ticket to access the sessions. Upgrade now to secure your seat.
Session Days
Day 4 - Friday, 13 February
Conference Tracks
AMR Leaders' Summit
Session Type
Presentation
Location
Al Ain J Stage